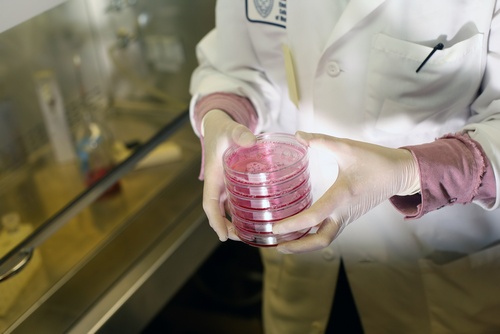
a lab technician walks across the laboratory holding several canisters with tissue samples.

Share this
how long can biological samples be stored before testing?
by Neoteryx Microsampling on Jun 22, 2017 7:00:00 AM
What You’ll Learn:
What You’ll Learn:
- How long biological samples—tissue, urine, and blood—can be safely stored before testing.
- Which factors most affect sample stability.
- Why temperature, preservatives, and storage duration are critical for reliable test results.
- How modern microsampling techniques may improve sample preservation and logistics.
What Determines How Long Biological Samples Can Be Stored?
The stability of biological specimens depends on multiple factors, sample type, temperature, storage conditions, and intended analysis. Each biospecimen (tissue, urine, or blood) contains unique molecular components that degrade at different rates. Understanding these differences ensures reliable results and preserves the scientific value of each sample.
1. Human Tissue Samples: How Long Can They Be Stored?

Tissue samples are widely used in genomics, toxicology, and pathology research. Their stability depends on how quickly they are preserved after collection and how they are stored.
- Frozen storage stability: Studies on adrenal, liver, and brain tissue show that mRNA and protein integrity can remain stable for several years when stored at –80°C.
- Chernobyl biobank example: Decades-old tissue samples stored under cryogenic conditions retained measurable RNA integrity, proving long-term viability when preserved appropriately.
- Formalin-fixed paraffin-embedded (FFPE) tissues are another standard for long-term histological analysis. However, FFPE can cause cross-linking that complicates downstream molecular assays.
Takeaway: Proper cryopreservation techniques and temperature control are key to maintaining tissue integrity for long-term biobanking and molecular testing.
2. Urine Samples: Storage Conditions and Longevity
 Urine samples are commonly analyzed for metabolic and toxicological studies. However, they are highly sensitive to environmental changes.
Urine samples are commonly analyzed for metabolic and toxicological studies. However, they are highly sensitive to environmental changes.
- Temperature control: Urine samples stored at 4°C can remain stable for up to 24–48 hours, but freezing at –20°C or –80°C extends stability to weeks or months.
- Preservatives: Adding stabilizing agents can prevent bacterial growth and analyte degradation during transport or delayed analysis.
- Freezing and thawing cycles: These can affect certain metabolites, particularly amino acids and hormones; therefore, minimizing freeze–thaw events is recommended.
Implications: For biobanking and population studies, it’s best to aliquot and freeze samples immediately after collection to maintain consistency in results.
3. Blood Samples: Stability Across Analytes
Blood is one of the most complex and commonly used biological matrices. Different analytes within blood have different stability profiles, depending on storage conditions and collection methods.
DNA and miRNA Stability
- DNA and miRNA – A study of serum samples from the Janus Serumbank revealed that even after 40 years, serum samples stored at -25°C are viable for whole-genome sequencing and SNP calling, as well as qPCR and small RNA sequencing, with 650 unique miRNAs detected, on average, in each sample.
Protein Stability
- Proteins – Stability of proteins in plasma varies from molecule to molecule; however, available evidence suggests that, when stored at -80°C for up to 6 years, proteins and other molecules in plasma samples do not degrade over time.
- However, at room temperature, protein degradation increases rapidly after 48 hours.
Small Molecules and Metabolites
- Small molecules – Another study of the serum samples at Janus Serumbank revealed that sodium, calcium, iron, and creatinine levels do not significantly change over time if the serum is stored at -25°C.
- Metabolites like glucose, lactate, and amino acids show variability depending on anticoagulant use and temperature.
- Immediate processing or freezing minimizes post-collection shifts in concentration.
Serum levels of other analytes, however, may be substantially altered over time; the study revealed a 26.4% increase in potassium levels and a 59.4% decrease in bilirubin levels after storage for 25 years.
Microsampling Applications
Recent studies highlight that dried blood microsamples, collected via devices like the Mitra® microsampler, can maintain analyte stability for weeks at ambient temperature. This eliminates the need for cold-chain logistics while maintaining data integrity, especially in remote sampling and decentralized research.
Best Practices for Biological Sample Storage
| Sample Type | Recommended Temperature | Typical Stability | Key Considerations |
| Tissue | –80°C to cryogenic | Years | Avoid freeze–thaw cycles |
| Urine | –20°C to –80°C | Weeks–Months | Add preservatives |
| Blood (Liquid) | –20°C to –80°C | Weeks–Years | Process quickly |
| Dried Blood Microsamples | Room Temperature | Weeks–Months | Stable for shipping and storage |
Smarter, Longer-Term Blood Sample Preservation

Biological sample stability is critical for reliable research outcomes. With proper protocols, tissues can last for years, urine for months, and blood for weeks to years depending on the analyte.
Innovations like Volumetric Absorptive Microsampling (VAMS®) are redefining how scientists store and transport blood samples, allowing ambient, stable storage without freezing. These advances make global studies more accessible, cost-effective, and environmentally sustainable.

Image Credits: Trajan, Neoteryx, Shutterstock
Share this
- Microsampling (206)
- Research, Remote Research (119)
- Venipuncture Alternative (105)
- Clinical Trials, Clinical Research (83)
- Mitra® Device (73)
- Therapeutic Drug Monitoring, TDM (51)
- Dried Blood Spot, DBS (39)
- Biomonitoring, Health, Wellness (30)
- Infectious Disease, Vaccines, COVID-19 (24)
- Blood Microsampling, Serology (23)
- Omics, Multi-Omics (21)
- Decentralized Clinical Trial (DCT) (20)
- Specimen Collection (18)
- Toxicology, Doping, Drug/Alcohol Monitoring, PEth (17)
- Skin Microsampling, Microbiopsy (14)
- hemaPEN® Device (13)
- Preclinical Research, Animal Studies (12)
- Pharmaceuticals, Drug Development (9)
- Harpera Device (7)
- Industry News, Microsampling News (5)
- Antibodies, MAbs (3)
- Company Press Release, Product Press Release (3)
- Environmental Toxins, Exposures (1)
- May 2026 (1)
- July 2025 (1)
- May 2025 (1)
- April 2025 (2)
- December 2024 (1)
- November 2024 (1)
- October 2024 (3)
- September 2024 (1)
- June 2024 (1)
- May 2024 (1)
- April 2024 (4)
- March 2024 (1)
- February 2024 (2)
- January 2024 (4)
- December 2023 (3)
- November 2023 (3)
- October 2023 (3)
- September 2023 (3)
- July 2023 (3)
- June 2023 (2)
- April 2023 (2)
- March 2023 (2)
- February 2023 (2)
- January 2023 (3)
- December 2022 (2)
- November 2022 (3)
- October 2022 (4)
- September 2022 (3)
- August 2022 (5)
- July 2022 (2)
- June 2022 (2)
- May 2022 (4)
- April 2022 (3)
- March 2022 (3)
- February 2022 (4)
- January 2022 (5)
- December 2021 (3)
- November 2021 (5)
- October 2021 (3)
- September 2021 (3)
- August 2021 (4)
- July 2021 (4)
- June 2021 (4)
- May 2021 (4)
- April 2021 (3)
- March 2021 (5)
- February 2021 (4)
- January 2021 (4)
- December 2020 (3)
- November 2020 (5)
- October 2020 (4)
- September 2020 (3)
- August 2020 (3)
- July 2020 (6)
- June 2020 (4)
- May 2020 (4)
- April 2020 (3)
- March 2020 (6)
- February 2020 (3)
- January 2020 (4)
- December 2019 (5)
- November 2019 (4)
- October 2019 (2)
- September 2019 (4)
- August 2019 (4)
- July 2019 (3)
- June 2019 (7)
- May 2019 (6)
- April 2019 (5)
- March 2019 (6)
- February 2019 (5)
- January 2019 (8)
- December 2018 (3)
- November 2018 (4)
- October 2018 (7)
- September 2018 (6)
- August 2018 (5)
- July 2018 (8)
- June 2018 (6)
- May 2018 (5)
- April 2018 (6)
- March 2018 (4)
- February 2018 (6)
- January 2018 (4)
- December 2017 (2)
- November 2017 (3)
- October 2017 (2)
- September 2017 (4)
- August 2017 (2)
- July 2017 (4)
- June 2017 (5)
- May 2017 (6)
- April 2017 (6)
- March 2017 (5)
- February 2017 (4)
- January 2017 (1)
- July 2016 (3)
- May 2016 (1)
- April 2016 (2)


Comments (1)